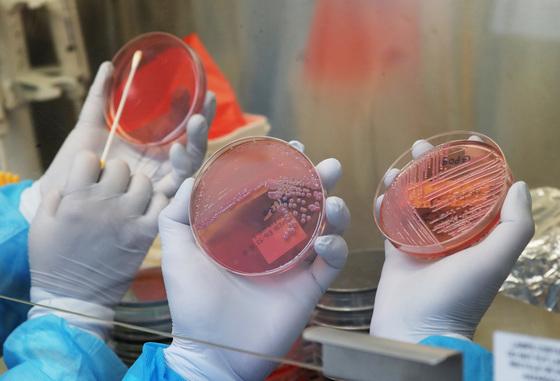
일주일 새 노로바이러스 환자 548명 발생…5년 내 최대

"식도암 로봇수술…구멍 하나만 뚫어도 안전, 환자 부담 줄여"
식도암 로봇수술에서 구멍을 여러 개 뚫는 경우와 한 개(싱글포트·단일공) 만으로 수술한 경우를 비교한 결과 완전 절제율, 수술 시간, 입원 중 통증, 수술 후 합병증 등에 차이가 없었다는 연구가 나왔다. 또 수술할 때 발생 가능한 출혈은 단일공 수술이 더 적었다.삼성서울병원은 박성용 폐식도외과 교수팀이 식도암 싱글포트 로봇수술 성적을 일본식도학회 학술지(Esophagus) 최근호에 발표했다고 17일 밝혔다.연구팀이 2024년 12월부터 2025